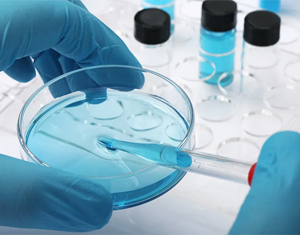

Doing our best
FOR LIFE
为深低温生物活性保存
提供高品质的试剂、仪器和服务
赛维尔生物科技有限公司以深低温玻璃化活性保存为核心技术,致力于保存生物资源活性,特别是人体细胞、组织、器官资源的完整生物活性,为医药产业提供颠覆性研发范式,为科学探索提供创新性研究手段,为宝贵生物资源储存与利用提供基础性平台。公司创始团队具有超过20年的行业经验,已经形成覆盖玻璃化保存全流程的试剂、工艺与设备解决方案,是全球首创可实现组织层面玻璃化保存的商业公司,技术水平全球领先。
Products and Solutions
产品与方案
全球领先的玻璃化深低温活性保存技术整体解决方案供应商